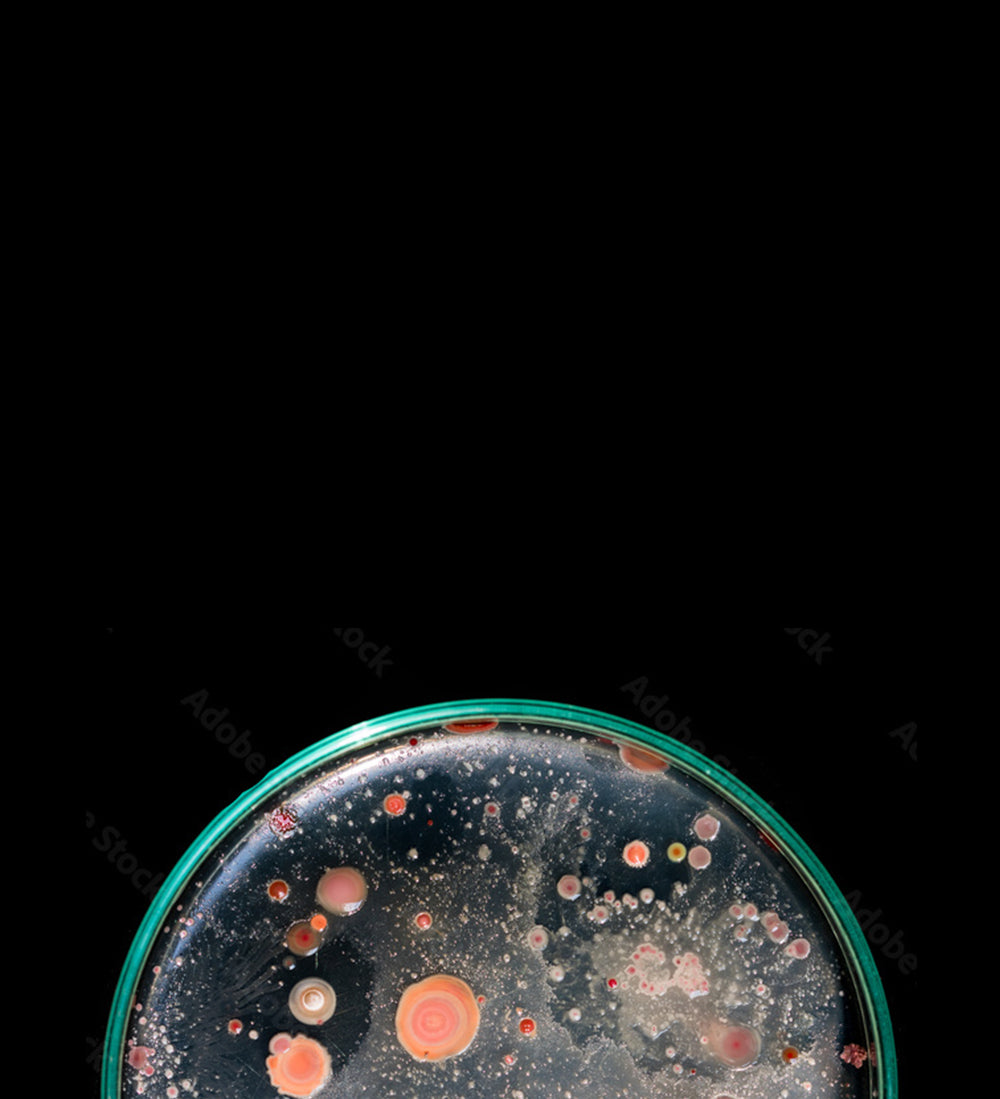
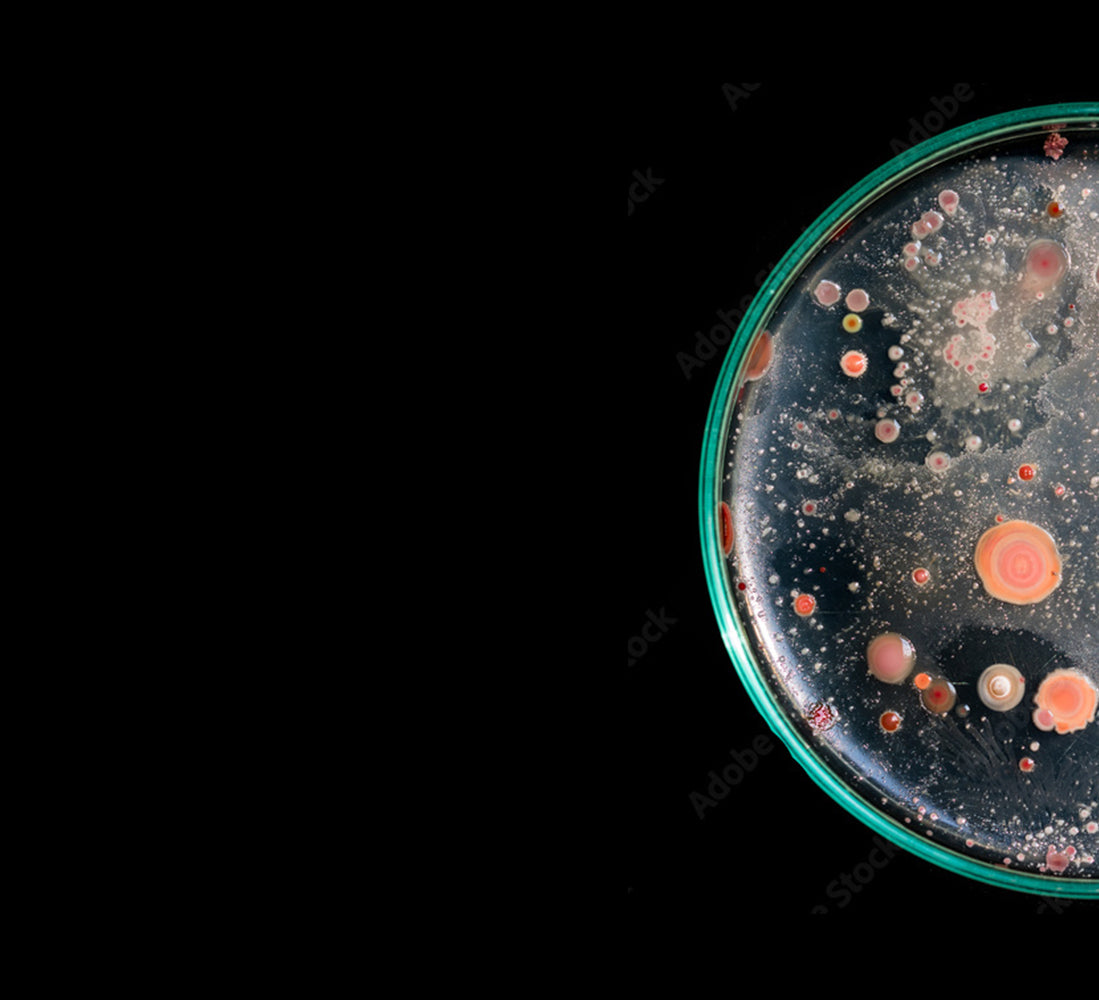

Our biodegradable materials are
going to help save the planet.
Phew.
THE MISSION
We hear the word ‘biodegradable’ a lot.
It sounds complicated, but it’s really very simple. A product that is made from biodegradable materials can break down and reintegrate with nature without causing any harm.

Biodegradable materials are the most sustainable materials.
That’s why we’re making them!
Most plastics are built to be so durable that they take centuries to fully biodegrade.
The plastic bottle that you drink from today won’t biodegrade until your great, great, great, great, great, great, great, great, great, great grandchild exists.
And if we don’t do something about that now, they won’t be very happy.
It can take up to 450 years for plastic to biodegrade.


WHY BIODEGRADATION?
Recycled trash needs to be separated to be effective,
and often those processes cause even more pollution.
We know the magic word that can help materials biodegrade
and reintegrate their elemental components into nature.
Microbes!
HOW IT WORKS
Microbe Power

- Our materials don’t just look good to you. They also look good to the 600 different microbes that exist in a landfill.


- These microbes consume the materials, then create enzymes that break down the material, making it easier for microorganisms to munch on the rest.
THE TEST
We achieved 100% biodegradation
of Banbū Leather in less than 250 days.
Go high five a microbe!

